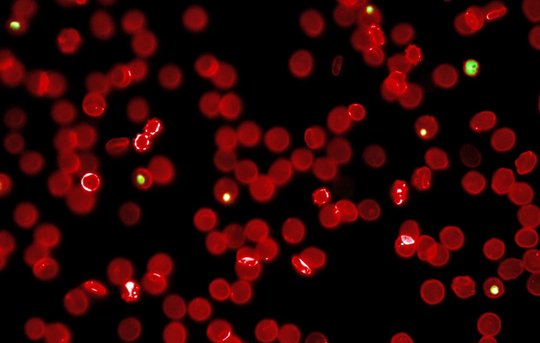
Das Bild zeigt rote Blutkörperchen unter dem Mikroskop

25. April 2018 – Welt-Malaria-Tag
Im Jahr 2016 registrierte die Weltgesundheitsorganisation (WHO) einen Anstieg der globalen Fallzahlen um 2,5 % auf insgesamt 216 Millionen im Vergleich zum Vorjahr. Mehr als zwei Drittel der rund 450.000 Todesfälle entfallen auf Kinder unter fünf Jahren. Der weitaus größte Anteil aller registrierten Malariainfektionen (90%) stammen aus Afrika südlich der Sahara.
Mehr als die Hälfte der über 90 Länder, in denen die Malaria endemisch ist, hat die von der WHO gesetztem Ziele hinsichtlich einer Reduzierung der Zahl der Neuinfekionen und der Todesfälle im Jahr 2016 nicht erreicht. Der erreichte Fortschritt innerhalb der letzten 10 Jahren scheint momentan gestoppt.
Zwar stehen einem Großteil der Bevölkerung in Afrika inzwischen verbesserte Diagnostik sowie wirksame Behandlungen zur Verfügung. Auf der anderen Seite sind prophylaktische Maßnahmen, wie der Schutz der Bevölkerung mit behandelten Moskitonetzen und die Verwendung von Moskitosprays für die Besprühung der Hauswände in vielen Regionen noch immer unzureichend.
Malariaforschung – Ein Eckpfeiler des Tropeninstituts
Das BNITM beschäftigt sich seit seiner Gründung mit der Diagnostik und Behandlung von Malaria. Bereits 1901 wurden Schiffs- und Kolonialärzte in Nachweismethoden geschult und rund 40% der von den Tropenmedizinern behandelten Patienten im damaligen Seemannskrankenhaus litten an der Malaria. 1905 entwickelte der Chemiker Gustav Giemsa eine neue Färbemethode, die noch heute zum Nachweis von Parasiten im Blutausstrich angewandt wird. Seit 1997 besteht in Ghana ein Forschungsbund Ausbildungszentrum (KCCR) in Zusammenarbeit mit der Kwame Nkrumah University of Science and Technology (KNUST), an dem zahlreiche Projekte zur Epidemiologie durchgeführt werden.
Im Jahre 2006 entdeckte Prof. Dr. Volker Heussler am BNITM ein bislang unbekanntes Stadium des Malaria-Erregers. Er beschrieb erstmals den Übergang des Parasiten von der Leber- in die Blutphase.
Heute beschäftigen sich Wissenschaflterinnen und Wissenschaftler aus den Gebieten Molekulare und Zelluläre Parasitologie, Immunologie, Epidemiologie und klinische Forschung mit verschiedenen Facetten der Malaria.

Erforschung von Interaktionen zwischen dem Parasit und dem Menschen
Unter Verwendung neuester mikroskopischer Darstellungsmöglichkeiten (in Zusammenarbeit mit dem Centre for Structural Systems Biology, CSSB) untersucht die Abteilung Zelluläre Parasitologie unter der Leitung von Prof. Tim Gilberger das Eindringen von Plasmodien in rote Blutkörperchen. 2017 konnte die Gruppe in Zusammenarbeit mit Wissenschaftlern aus den USA zeigen, dass insbesondere spezielle Kalium-abhängige Prozesse für das Eindringen verantwortlich sind (Kumar et al., 2017).
Dem Umbau der roten Blutkörperchen durch den Malariaparasiten hat sich die Gruppe von Dr. Tobias Spielmann gewidmet. Sie untersuchen mithilfe modernster zellbiologischer und molekularbiologischer Methoden unter anderem den hierfür zugrunde liegenden Transport von Eiweißen aus dem Parasiten in die Blutzelle. Die Gruppe konnte zuletzt eine Methode etablieren, mit der durch genetische Manipulation die Funktion einzelner Gene im Parasiten analysiert werden kann. Unter anderem konnte die Gruppe das Resistenzgen gegen das derzeit wichtigste Therapeutikum Artemesinin, Kelch 13, identifizieren und ausschalten (Birnbaum et al., 2017).


Prof. Iris Bruchhaus untersucht mit ihrer Arbeitsgruppe unter anderem den Mechanismus der Anhaftung infizierter roter Blutkörperchen an die Blutgefäße. Diese Anhaftung ermöglicht es dem Parasiten der Eliminierung durch das Immunsystem zu entgehen, hat allerdings erhebliche Komplikationen für den Menschen, wenn Kapillaren in Organen, wie dem Gehirn, betroffen sind. Einige der hierfür essentiellen Bindungsmoleküle wurden nun am BNITM identifiziert und könnten zukünftig für neuartige Therapiekonzepte genutzt werden (Metwally et al., 2017).
PD Dr. Thomas Jacobs setzt sich in seiner Arbeitsgruppe unter anderem mit der Abwehrreaktionen auf Infektionen mit den Malariaparasiten auseinander. Dabei wird die Immunregulation sowohl im Tiermodell als auch in Feldstudien an infizierten Patienten untersucht. Der Fokus seiner Forschung liegt dabei auf der Regulation von T-Zellen, die sowohl eine schützende als auch eine verstärkende Wirkung haben können. Im letzten Jahr konnten sie eine Gruppe von regulatorischen T-Zellen identifizieren, die die Entwicklung der Malaria beeinflussen kann (Mackroth et al. 2017, Abel et al. 2018).

Epidemiologische Studien zur Verbesserung der Diagnostik und Bildung von Kompetenzen

Die Abteilung Infektionsepidemiologie beschäftigt sich hauptsächlich mit der räumlichen und zeitlichen Verbreitung von Infektionskrankheiten in ressourcenknappen Gegenden. Die Gruppe arbeitet derzeit an der Verbesserung der Spezifität der Malariadiagnostik zur verlässlichen Unterscheidung von Malaria und anderen Ursachen schwerer Infektionskrankheiten. In der “RAPID-Mal”-Studie wird in Kooperation mit dem Fraunhofer-Institut hierzu ein Schnelltest auf der Basis eines Biochip-basierten Gerätes entwickelt und evaluiert. Eine aktuelle Studie der Gruppe zu Ko-Infektionen bei Malaria-infizierten Kindern in Ghana zeigte die Wichtigkeit einer schnellen und sicheren Diagnostik für eine adäquate Behandlung der nicht-parasitären Infektionen (Hogan et al., 2018).
Eigens angelegte internationale Ausbildungsprogramme (GIBACHT, EpiCID Short Course) in den Bereichen Epidemiologie und Biosicherheit sollen helfen, die Entwicklung von Ressourcen in den betroffenen Ländern zu unterstützen.
Klinische Forschung – Zwischen genetischer Variabilität und neuen Wirkstoffen
In den vergangenen Jahren widmete sich die klinische Forschung überwiegend der Suche nach angeborenen Faktoren, die Menschen eine natürliche Resistenz gegen schwere Komplikationen der Malaria verleihen. Prof. Rolf Horstmann und seine Gruppe haben durch Vergleiche der Varianten im Genom lebensbedrohlich erkrankter und gesunder afrikanischer Kinder einige solcher Faktoren ermittelt, deren funktionelle Einflüsse aber noch untersucht werden müssen.
Anfang 2018 übernahm Prof. Michael Ramharter die Leitung der klinischen Forschung am Institut und legte den Schwerpunkt der klinischen Malariaforschung auf Studien zur Wirksamkeit neuer Medikamente oder Medikamentenkombinationen, wie z.B. alternativer Artemisinin-Kombinationspräparate, insbesondere bei Kindern in Afrika.
In Verbindung stehende Artikel:
Zahlreiche Anlagerungsstellen für Malariaparasiten an der Wand kleiner Blutgefäße - 08.08.2016 01:26
Bedingungen der Laborzüchtung verändern Eigenschaften von Malariaparasiten - 08.08.2016 01:16
Das Skelett der Malariaparasiten - 13.11.2014 16:04
Entzündung zerstört rote Blutkörperchen - 18.02.2014 13:43
Immunschwäche bei Malaria - 18.02.2014 13:29
Nur im Menschen, nicht im Reagenzglas - 18.02.2014 13:03
Malariaparasit in 3D gefilmt - 18.02.2014 12:07
Malariaparasiten nutzen Abwehrreaktion von Leberzellen - 09.12.2013 10:08
Signal zur Invasion roter Blutkörperchen - 15.06.2010 11:02
Großangriff auf den Lebenszyklus von Malariaparasiten - 08.02.2010 12:07
Ansprechperson
Dr. Eleonora Schönherr
Presse- & Öffentlichkeitsarbeit
Telefon : +49 40 285380-269
E-Mail : presse@bnitm.de